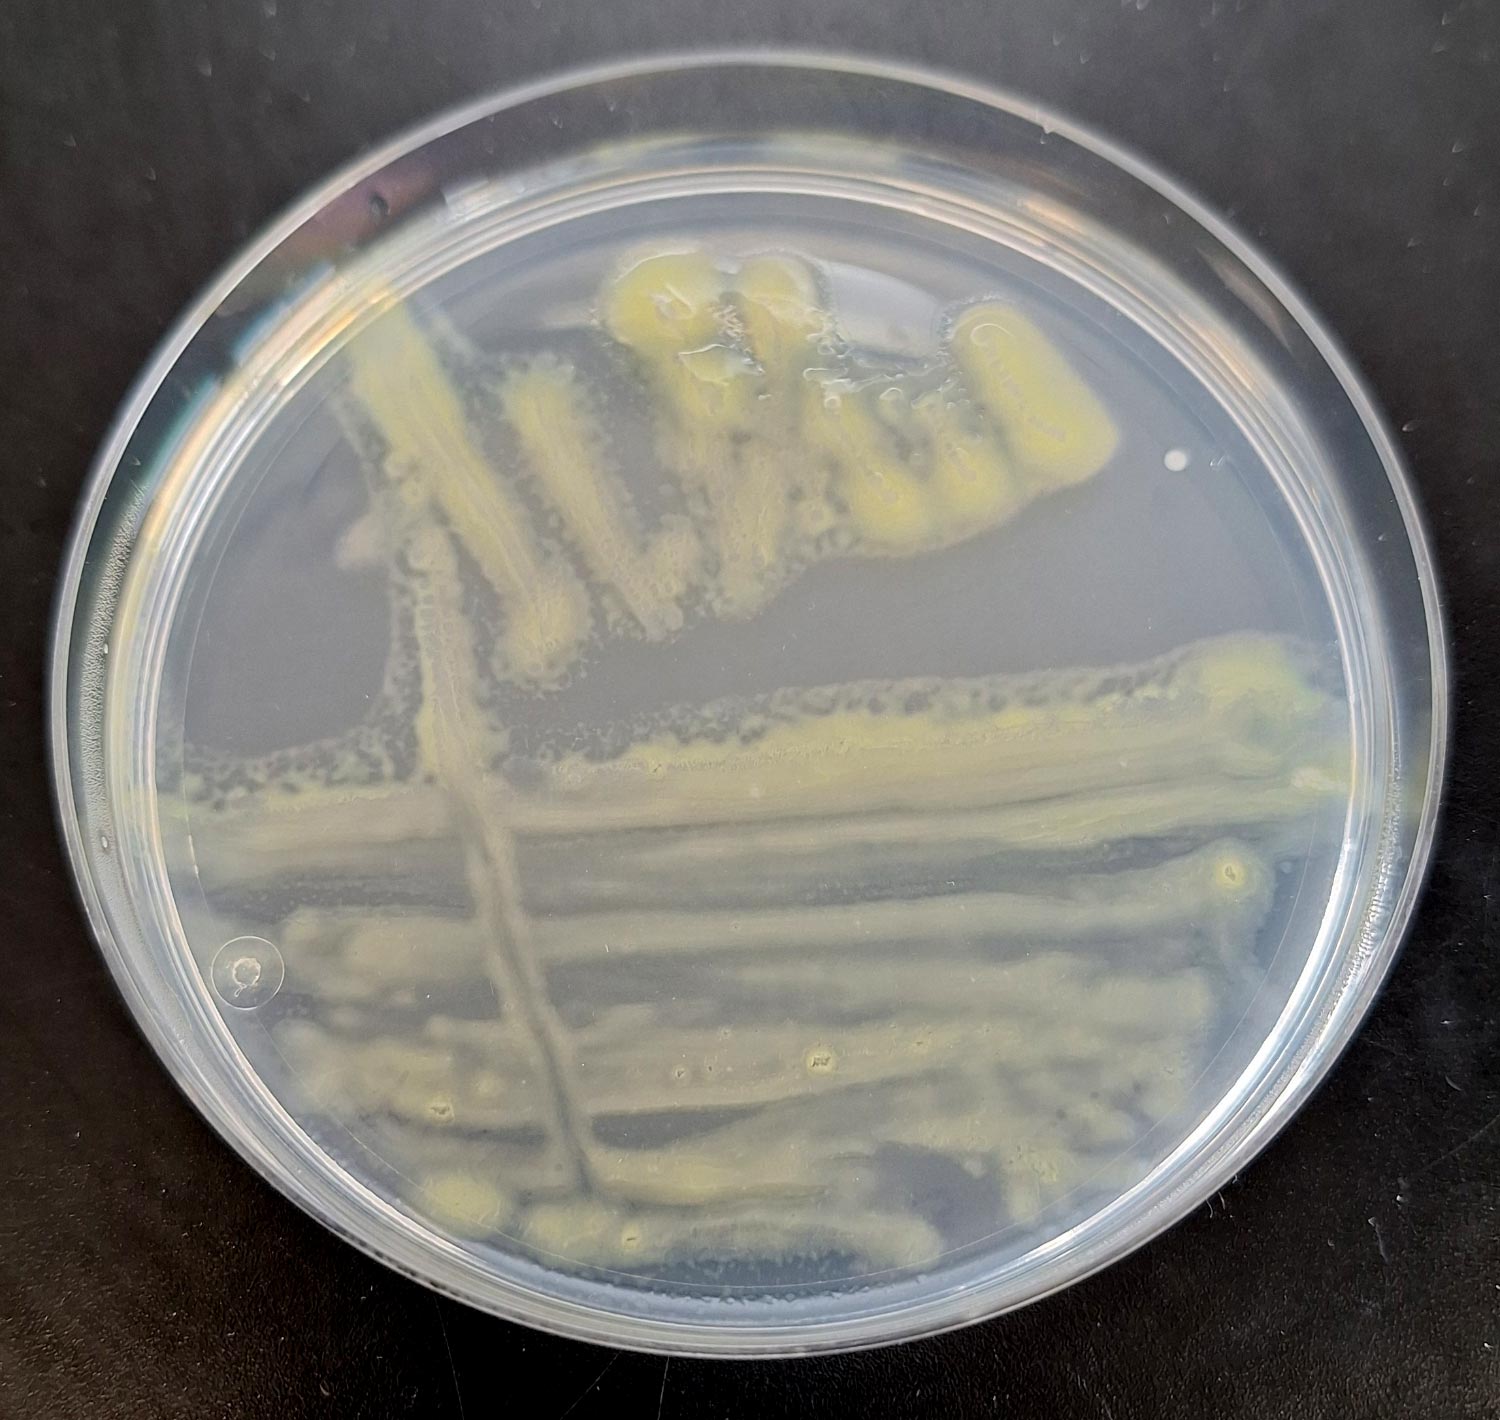

Columnariskrankheit bei Koi und Aquarienfischen
Der Erreger der Columnariskrankheit ist Flavobacterium (F.) columnare, ein Bakterium, das besonders im Zierfischhandel eine große Rolle spielt. Flavobacterium columnare ist ein gramnegatives, stäbchenförmiges Bakterium mit einer Größe von 5–12 x 0,5 µm, das sich langsam gleitend fortbewegt, jedoch nicht über Geißeln verfügt. Flavobacterium columnare wurde unter anderem bei beliebten Aquarienfischen wie Neon (Paracheirodon innesi), Platy (Xiphophorus maculatus) und Zebrabärbling (Danio rerio) aber auch bei Teichfischen wie Koi (Cyprinus carpio) nachgewiesen.
Grundsätzlich kann der Erreger aber bei allen Süßwasserfischen vorkommen, wobei Krankheitsausbrüche bei Teichfischen vor allem in den Sommermonaten auftreten, wenn die Wassertemperaturen höher liegen. Eintrittspforte für den Erreger sind Verletzungen der Haut. Weiterhin wird eine Infektion durch schlechte Wasserqualität, hohe Ammoniak-Konzentrationen, einen hohen pH-Wert und einen geringen Sauerstoffgehalt begünstigt. Es bilden sich zunächst kleine, weißliche Stellen am Maul, den Schuppenrändern und den Flossen, die beim Größerwerden an Schimmel erinnern. Bei schuppenlosen Fischen wie getüpfelten Gabelwelsen (Ictalurus punctatus) beginnt die Infektion als kleine blau-graue Nekrose in der Haut mit einem rötlich entzündeten Wundrand. Mikroskopisch lassen sich große Mengen F. columnare Bakterien sowohl im Zentrum als auch am Wundrand nachweisen, wobei der Rand mikroskopisch häufig fast nur aus Bakterienzellen zu bestehen scheint. Bei Fischen mit Schuppen können die Veränderungen an den äußeren Rändern der Flossen beginnen und breiten sich nach innen über den Körper aus, wobei die Läsionen an das Erscheinungsbild eines Sattels erinnern. Daher auch die Bezeichnung „saddleback disease“. Zunächst kommt es zur Zersetzung der Flossenränder, so dass die Flossenstrahlen bloß liegen. Auch die Kiemen können befallen werden. Dabei lösen sich die Kiemenblätter von der Spitze zu den Kiemenbögen auf. Bei Jungfischen kommt es oftmals zum Verkleben der Kiemenblättchen durch übermäßige Schwellung des Kiemenepithels und zu starker Schleimbildung. Die Folge ist eine verminderte Sauerstoffaufnahme, die zu schnellen Atembewegungen führt.
-
Abb. 1: Flavobacterium columnare-Kolonien auf Anacker-Ordal Agar
Bildquelle: LABOklin
-
Abb. 2: Panzerläsionen durch Emydomyces testavorans bei einer Wasserschildkröte
Bildquelle: C. Leineweber
Bei der Columnariskrankheit können 2 Verlaufsformen unterschieden werden. Bei der chronischen Form vergrößern sich die weißen Läsionen sehr langsam und die Fische sterben erst nach längerer Zeit. Bei der akuten Form breiten sich die Hautveränderungen binnen weniger Stunden aus. Es können bis zu 50 % des Fischbestands innerhalb von 36 Stunden sterben. In Infektionsversuchen mit Zebrabärblingen (Danio rerio) konnte bereits 24 Stunden nach experimenteller Infektion die Bildung charakteristischer Läsionen am Rücken beobachtet werden. Eine Therapie muss daher sehr schnell erfolgen.
Eine antibiotische Behandlung nach Antibiogramm ist grundsätzlich möglich. Sie sollte jedoch immer in Kombination mit einer Optimierung der Haltungsbedingungen erfolgen. Da der Erreger ein alkalisches Milieu bevorzugt, kann das Absenken des pH-Wertes auf 6,8 die Behandlung unterstützen.
Zur Diagnose wird ein Abstrich betroffener Körperstellen genommen. Dieser kann sowohl kulturell als auch mittels PCR untersucht werden. Auf Anacker-Ordal-Agar wächst F. columnare in blassgelben Kolonien bei 18°C–30°C (Abb. 1), wobei es zur Anheftung am Agar neigt. Bei Temperaturen unter 14°C und über 33°C kommt es unter Kulturbedingungen zu keinem Wachstum mehr. Die kulturelle Untersuchung bietet die Möglichkeit ein Antibiogramm anzufertigen. Der Vorteil der PCR liegt in einer kürzeren Bearbeitungszeit und einer deutlich höheren Sensitivität durch das Detektieren von DNA. Zudem besteht die Möglichkeit von betroffenen Flossenbereichen ein kleines Stück abzuschneiden und mikroskopisch zu untersuchen. Dabei zeigt sich, dass viele der Columnaris-Bakterien sich mit einem Ende festhängen und mit dem freien Ende schwingende Bewegungen ausführen. Am Rand der entzündeten Gewebestellen ballen sie sich zu säulen- oder häufchenförmigen Gebilden zusammen.
Emydomyces testavorans – ein Hautpilz bei Schildkröten
Emydomyces testavorans ist ein keratinophiler Pilz, der bei Süßwasserschildkröten vorkommt. Er gehört zur Ordnung Onygenales, zu der auch andere reptilienassoziierte Pathogene zählen wie die Gattungen Nannizziopsis, Ophidiomyces und Paranannizziopsis, welche bei verschiedensten Reptilienarten v. a. mit Hautkrankheiten assoziiert sind.
Emydomyces testavorans wurde erstmals im Zusammenhang mit ulzerativen Panzerläsionen bei Wasserschildkröten im Westen der USA beschrieben (Woodburn et al. 2019). Seither wurde er bei mehreren Spezies in Nordamerika nachgewiesen (Woodburn et al. 2019, Davidson et al. 2025, Brunner et al. 2024, Fredrickson et al. 2024). Die bisherige Forschung und auch die Nachweise von Emydomyces testavorans bei Schildkröten stammt bisher ausschließlich aus Nordamerika, wo der Pilz sowohl in Zoo- als auch in Wildpopulationen von Süßwasserschildkröten nachgewiesen wurde.
Klinisch und pathologisch werden v. a. ulzerative Panzerläsionen beschrieben (Abb. 2), die auch tiefliegende Panzerschichten betreffen können. In ausgeprägten Fällen können sich epitheliale Einschlusszysten bilden, die in die Tiefe reichen und mittels Computertomographie dargestellt werden können. Bei milderen Fällen kommen helle Stellen am Panzer vor. Chronische Verläufe mit langsamen progressiven klinischen Veränderungen am Panzer sind beschrieben. Histologisch können bei betroffenen Tieren Plattenepithelmetaplasie, Hyperkeratose, Entzündung und Osteonekrose festgestellt werden (Woodburn et al. 2021).
Eine Behandlung ist schwierig und langwierig und umfasst sowohl die Behandlung mit Antimykotika, v. a. Terbinafin, als auch die regelmäßige Reinigung und Desinfektion der Umgebung. Effektive Desinfektionsmittel scheinen Chlorbleiche, Chlorhexidin oder beschleunigte Wasserstoffperoxide zu sein (Liszka et al. 2025).
Die Diagnostik von Emydomyces testavorans ist häufig schwierig. Die Darstellung typischer Einschlusszysten am Panzer mittels Computertomographie kann in schweren Fällen einen Hinweis auf eine Infektion geben. Der Pilz lässt sich aber nur schwer kultivieren und wird häufig von anderen Pilzen, die auch auf dem Panzer oder in der Umwelt vorkommen, in der Kultur überwuchert. Oberflächenläsionen enthalten häufig keine Pilze mehr und Proben aus tiefliegenden Schichten sind zum Teil schwer zu entnehmen. Zu empfehlen ist daher eine kombinierte Tupferprobenentnahme von Rachen, Kloake und Panzer. Der trockene Tupfer ohne Medium kann dann mittels PCR auf Emydomyces testavorans getestet werden. Seit kurzem hat Laboklin eine PCR zum Nachweis von Emydomyces testavorans etabliert, so dass die Diagnose dieses Erregers nun auch in Europa möglich ist. In den letzten Monaten erfolgten auch schon einige Nachweise bei verschiedenen Süßwasserschildkröten in Deutschland, sodass feststeht, dass der Erreger auch hier vorkommt und zu Problemen führen kann.
Dr. Martin Felten, Dr. Christoph Leineweber,
Dr. Rachel Marschang
Weiterführende Literatur
-
Untergasser D. Krankheiten der Zierfische. Ettlingen (DE): Dähne Verlag; 2024.
Buller NB. Bacteria and fungi from fish and other aquatic animals: a practical identification manual. 2nd ed. Oxfordshire (UK): CABI; 2014. -
Simmons A, Brunner T, Ospina E, Wong A, Keller K, Adamovicz L. Emydomyces testavorans DNA is detected from shell swabs of companion chelonians. J Exot Pet Med. 2024;50:49–53. doi:10.1053/j.jepm.2024.05.005.
-
Davidson A, Kendall MW, Ryan M, Ladez K, Bradley S, Lionetto C, Graser W, Glowacki G, Thompson D, King RB, Golba CK, Moorhead K, Adamovicz L, Allender MC. Hematology, Plasma Biochemistry, Protein Electrophoresis, and Pathogen Surveillance in Headstarted and Wild-Reared Populations of Blanding‘s Turtles (Emydoidea blandingii) in Three Northern Illinois, USA, Counties. J Wildl Dis. 2023 Dec 20;61(1):30-45. doi: 10.7589/JWD-D-23-00194
-
Fredrickson K, Adamovicz L, Terio K, Davidson A, Ryan M, Waligora M, Schroder K, Bradley S, Lionetto C, Andersson K, Engel A, Graser W, Anchor C, Glowacki G, Allender MC. Emydomyces testavorans Surveillance in Multiple Free-Ranging Terrestrial and Aquatic Chelonian Species in Illinois, USA. J Wildl Dis. 2024 Oct 1;60(4):850-859. doi: 10.7589/JWD-D-23-00164
-
Liszka NC, Adamovicz L, Moorhead KA, Daleo MJ, Grochowski K, Allender MC. Evaluating the Efficacy of Disinfectant Methods against Emydomyces testavorans, a Fungus Associated with Shell Disease in Freshwater Aquatic Turtles. J Wildl Dis. 2025 Jan 1;61(1):234-240. doi: 10.7589/JWD-D-24-00094.
-
Woodburn DB, Miller AN, Allender MC, Maddox CW, Terio KA. Emydomyces testavorans, a New Genus and Species of Onygenalean Fungus Isolated from Shell Lesions of Freshwater Aquatic Turtles. J Clin Microbiol. 2019 Jan 30;57(2):e00628-18. doi: 10.1128/JCM.00628-18
-
Woodburn DB, Kinsel MJ, Poll CP, Langan JN, Haman K, Gamble KC, Maddox C, Jeon AB, Wellehan JFX, Ossiboff RJ, Allender MC, Terio KA. Shell Lesions Associated With Emydomyces testavorans Infection in Freshwater Aquatic Turtles. Vet Pathol. 2021 May;58(3):578-586. doi: 10.1177/0300985820985217